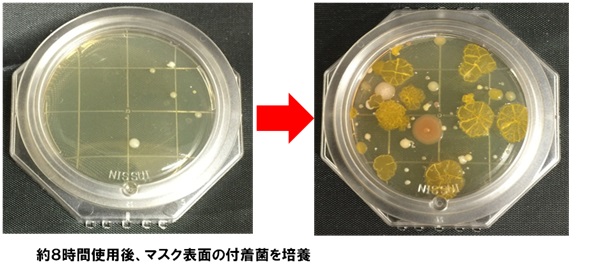
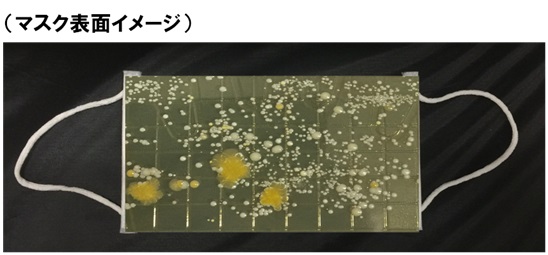

先週まではわりとノーマスクの人も増えていたけど、
さっき昼休みで外に出たら、またマスク率が高まっていた。
涼しくなったのもあるし、飛行機の件も効いてると思う。
だけど私、医療関係者の方が、
「マスクってめちゃくちゃ汚染されているのに、
こんな日常的につけたり外したりして、
あっちこっちに汚染広げてるとしか思えないけど
大丈夫かいな?」
とよく言っているので、ずっと気になっていたんですね。
で、これ・・・数年前の検証写真なんですけどね。
マスクの表面には基本的に菌やウイルスがうようよしていて、
たとえば一日8時間使用したマスクの表面の付着菌を培養
すると、こうなっちゃうんですって。

マスクって基本的に不潔なものだと思うんですよね。
だけど、街中でも仕事中でも飛行機内でも新幹線車内でも、
マスクがずれてきたのが気になって、
ちょっとさわって調整したりして、
その手で、手すりや椅子や机にさわったりしてるわけですね。
食事の前にマスクをはずして、ビニール袋やらカバンやら
ポケットやらにしまって、
その手で顔をぽりっとかいたり、髪をかきあげたりして、
そして食事が終わったら、また取り出してつけたりして、
もう、めっちゃ不衛生なわけですね。
マスクを強要するムードって、
ものすごく不潔を推奨してると思うんですね。
ほんと、現実を見て、考え直したほうがいいと思うんですよね。